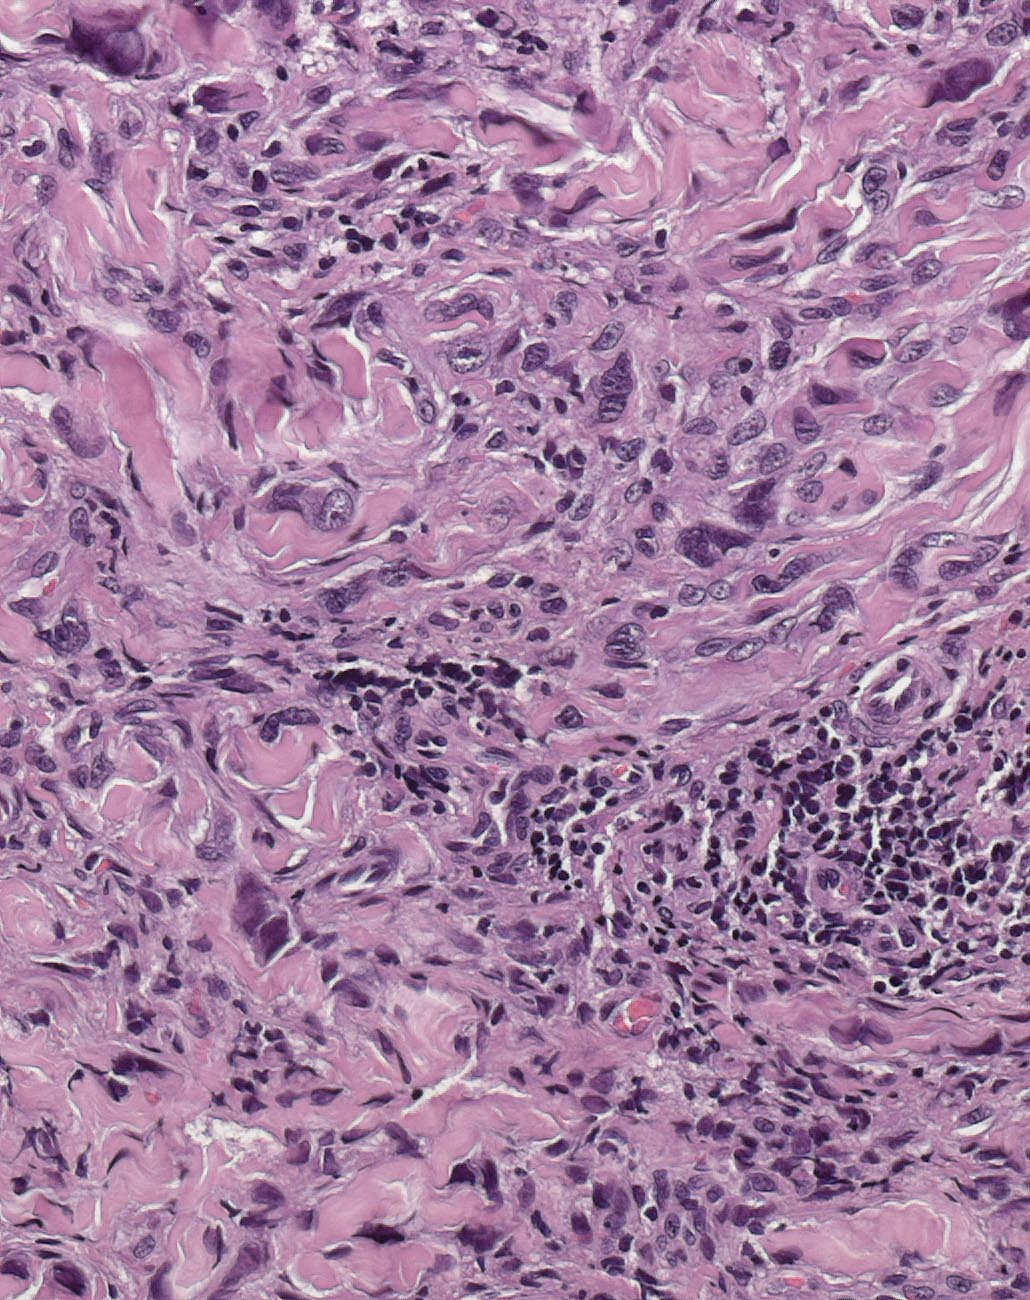
Pathorama

Patalom es un pueblo ubicado en el distrito de Kaposvár, en el condado de Somogy, Hungría.[2][3]
Superficie
Posee una superficie de 6,680 kilómetros cuadrados.[2]
Demografía
Hasta 2019 la población era de 304 habitantes,[3] con una densidad de población de 45,51 habitantes por kilómetro cuadrado.[2]
Referencias